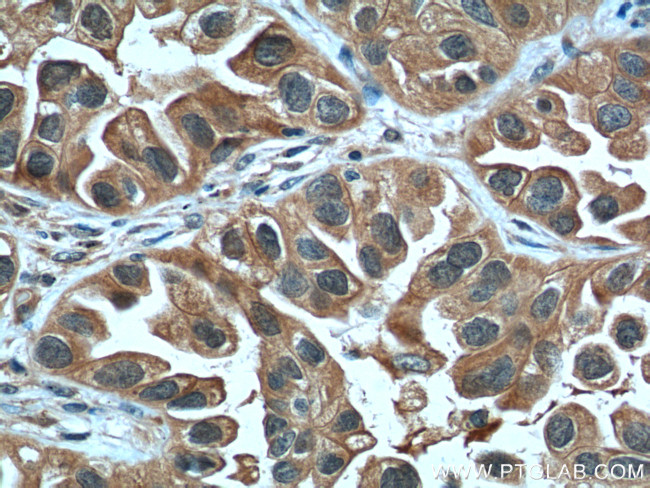
LIF Antibody in Immunohistochemistry (Paraffin) (IHC (P))

Search
Proteintech
LIF Polyclonal Antibody
{{$productOrderCtrl.translations['antibody.pdp.commerceCard.promotion.promotions']}}
{{$productOrderCtrl.translations['antibody.pdp.commerceCard.promotion.viewpromo']}}
{{$productOrderCtrl.translations['antibody.pdp.commerceCard.promotion.promocode']}}: {{promo.promoCode}} {{promo.promoTitle}} {{promo.promoDescription}}. {{$productOrderCtrl.translations['antibody.pdp.commerceCard.promotion.learnmore']}}
产品信息
26757-1-AP
种属反应
宿主/亚型
分类
类型
抗原
偶联物
形式
浓度
规格
纯化类型
保存液
内含物
保存条件
运输条件
产品详细信息
Immunogen sequence: ITPVNATCA IRHPCHNNLM NQIRSQLAQL NGSANALFIL YYTAQGEPFP NNLDKLCGPN VTDFPPFHAN GTEKAKLVEL YRIVVYLGTS LGNITRDQKI LNPSALSLHS KLNATADILR GLLSNVLCRL CSKYHVGHVD VTYGPDTSGK DVFQKKKLGC QLLGKYKQII AVLAQAF (27-202 aa encoded by BC093733)
靶标信息
Leukemia inhibitory factor (LIF) is a 20 kDa protein that belongs to the IL-6 receptor family. It binds to a heterodimeric membrane receptor made up of a LIF-specific subunit, gp190 or LIFR, and the subunit gp130, which is shared with the other members of the IL-6 family. LIF expression has been observed in various tissues including thymus, lung, and neuronal tissue. LIF can be up-regulated by pro-inflammatory cytokines such as TNFα and IL-17, and elevated levels of LIF have been found in cases of rheumatoid arthritis, neural injury, systemic inflammation, and tuberculosis. LIF displays diverse biological effects, but is best known for its ability to inhibit the differentiation of embryonic stem cells in mice and contribute to stem cell self-renewal.Human and mouse LIF share 79% sequence homology and exhibit cross-species activity. However, LIF inhibition of stem cell differentiation appears to be mouse-specific.
仅用于科研。不用于诊断过程。未经明确授权不得转售。
生物信息学
蛋白别名: cholinergic differentiation factor; D factor; differentiation inhibitory activity; differentiation-inducing factor; Differentiation-stimulating factor; hepatocyte-stimulating factor III; human interleukin in DA cells; Leukemia inhibitory factor; LIF; Melanoma-derived LPL inhibitor; MLPLI; myeloid leukaemia inhibitory factor; unnamed protein product
基因别名: CDF; DIA; HILDA; LIF; MLPLI
UniProt ID: (Human) P15018, (Mouse) P09056
Entrez Gene ID: (Human) 3976, (Mouse) 16878